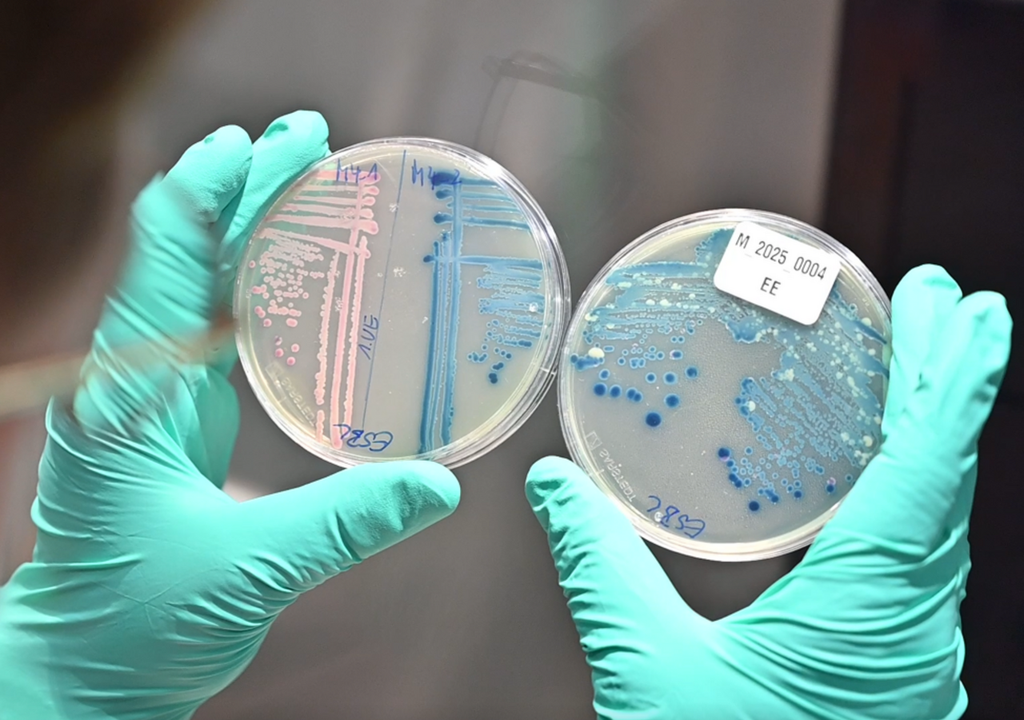
Anzucht multiresistenter E. coli-Bakterien aus Wasserproben. Bild: Josef Wund Stiftung

„Wir müssen frühzeitig handeln“: Antibiotikaresistente Bakterien in der Ostsee entdeckt
Antibiotikaresistenzen gelten inzwischen als eines der größten Gesundheitsprobleme weltweit. Doch die Gefahr beschränkt sich nicht allein auf Krankenhäuser oder Pflegeheime. Auch in Flüssen, Seen und sogar im Meer tauchen resistente Keime auf.
Antibiotikaresistenzen stellen im 21. Jahrhundert eine der größten Gefahren für die menschliche Gesundheit dar. In Europa erkrankten laut RKI im Jahr 2016 insgesamt rund 680.000 Menschen durch resistente Erreger, im Jahr 2019 sogar 860.000 Menschen. Das Risiko, mit solchen Keimen in Kontakt zu kommen, beschränkt sich jedoch längst nicht mehr nur auf Krankenhäuser.
Im Greifswalder Bodden haben Forschende nun sogar antibiotikaresistente Bakterien im Oberflächenwasser nachgewiesen. Bedenklich daran ist, dass die Proben an einem beliebten Badestrand entnommen wurden. „Wir müssen frühzeitig handeln, 5 nach 12 ist es zu spät“, warnt Mikrobiologin Prof. Katharina Schaufler vom Helmholtz-Institut für One Health (HIOH) in Greifswald. Zwar bestehe derzeit keine akute Gefahr für Badende, doch die Studienergebnisse weisen darauf hin, dass sich das Problem allmählich verschärft.
Eine stille Pandemie
Im Fachjargon sprechen Wissenschaftler von einer stillen Pandemie. Damit ist ein langsames, globales Fortschreiten von Antibiotikaresistenzen gemeint.
Der Selektionsdruck begünstige resistente Stämme, die sich in Krankenhäusern, in der Gemeinschaft und eben auch in der Umwelt ausbreiten, erklärt Schaufler. Im Gegensatz zu COVID-19 gehe es hier nicht um einen einzelnen Erreger, dessen Verbreitung plötzlich eskaliert, sondern um ein ganzes Spektrum resistenter Bakterien.
„Eine akute Krise wie in der Corona-Pandemie besteht derzeit nicht, doch die Belastung mit antibiotikaresistenten Bakterien steigt kontinuierlich an“, so Schaufler. Ohne Gegenmaßnahmen drohten künftig häufiger schwer behandelbare Infektionen.
Todesfälle in erschreckender Zahl
Wie real die Gefahr bereits ist, zeigt der internationale Vergleich. Für Deutschland wurden allein für das Jahr 2019 fast 10.000 Todesfälle direkt durch resistente Infektionen geschätzt. In rund 45.000 weiteren Fällen hatten Resistenzen den Krankheitsverlauf erschwert.
Weltweit belaufen sich die Schätzungen auf 1,27 Millionen Todesfälle, in denen Resistenzen direkt ursächlich waren, und fast fünf Millionen, bei denen sie immerhin beteiligt waren. Die Zahlen würden zeigen, dass die Mortalität bereits heute relevant ist, sagt Schaufler.
Spuren im Ostseewasser
Das HIOH hat untersucht, in welchem Ausmaß resistente Keime in der Natur vorkommen. Dafür nahm Schauflers Team Wasserproben an drei Standorten im Greifswalder Bodden: in der Nähe eines Klärwerks, an einem Badestrand sowie auf der abgeschirmten Insel Riems. Als Modellorganismus diente Escherichia coli.

In sämtlichen Proben ließen sich resistente Stämme nachweisen, teils sogar multiresistente Varianten, so das Ergebnis. Die höchsten Konzentrationen fanden sich erwartungsgemäß in Klärwerksnähe, doch selbst im offenen Badebereich war das Wasser belastet.
Besonders bemerkenswert sei, dass die Keime auch dort vorkamen, wo keine Antibiotikarückstände messbar waren, so Schaufler. Das bedeute, dass ein ständiger Selektionsdruck nicht notwendig sei, um resistente Stämme in der Umwelt zu erhalten.
Keine Panik, aber Vorsicht
Eine akute Gesundheitsgefährdung für Badegäste leiten die Forschenden aus ihren Messungen nicht ab. Die Wasserqualität liege im Rahmen gängiger Richtwerte. Dennoch gibt es Einschränkungen: „Mit größeren Wunden oder ausgeprägter Immunschwäche sollte man allerdings nicht ins Wasser gehen, denn in diesen Fällen ist eine Infektion nicht auszuschließen“, so Schaufler.
Die Ergebnisse weisen außerdem auf Handlungsbedarf in der Abwasserwirtschaft hin. Heute verfügen Klärwerke in der Regel über drei Reinigungsstufen. Um die Zahl multiresistenter Keime zu senken, könnte sich eine vierte Stufe, etwa durch Ozonierung oder Aktivkohle, als sinnvoll erweisen.
Verantwortung von Medizin und Landwirtschaft
Die entscheidende Stellschraube bleibt jedoch der Umgang mit Antibiotika selbst. „Wichtig ist, die Anwendung von Antibiotika auf das erforderliche Minimum zu reduzieren“, erklärt Schaufler. In der Humanmedizin würden die Präparate nach wie vor bei banalen viralen Infekten verschrieben, obwohl sie dort wirkungslos sind. Auch in der Tierhaltung und Landwirtschaft sei der Einsatz noch zu hoch.
Die Forscherin verweist auf das Konzept des Antibiotic Stewardship, also den verantwortungsvollen Einsatz von Antibiotika. Nur wenn Ärzte, Landwirte, Patienten und Politik gemeinsam an einem Strang ziehen, lasse sich das Problem eindämmen.
Das Helmholtz-Institut für One Health verfolgt dabei einen ganzheitlichen Ansatz, indem es neben Mensch und Tier auch die Umwelt als Reservoir für Krankheitserreger untersucht. „Gesundheit muss im großen Kontext gedacht werden“, so Schaufler. Denn resistente Keime kennen keine Grenzen – weder geografisch noch zwischen Ökosystemen.
Quellenhinweis:
Lübcke, P., Heiden, S. E., Homeier-Bachmann, T., et al. (2024): Multidrug-resistant high-risk clonal Escherichia coli lineages occur along an antibiotic residue gradient in the Baltic Sea. npj Clean Water, 7, 94.
Verpassen Sie nicht die neuesten Nachrichten von Meteored und genießen Sie alle unsere Inhalte auf Google Discover völlig KOSTENLOS
+ Folgen Sie Meteored



